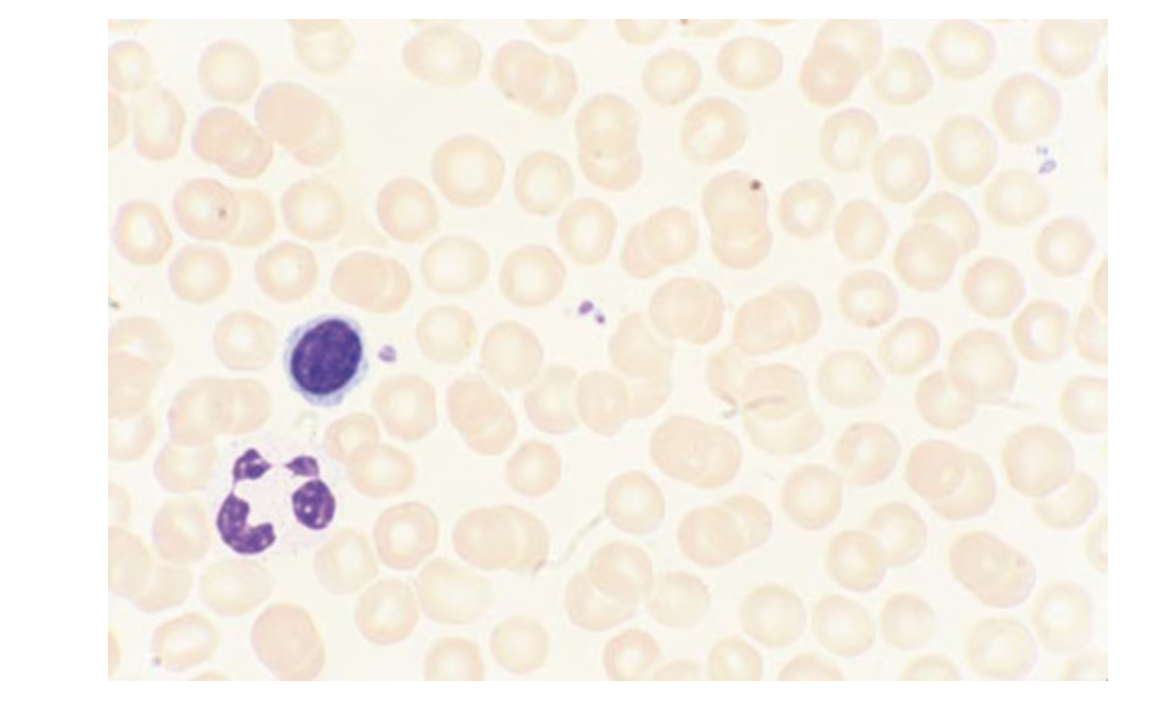

Physician Task: Applying Foundational Science Concepts > Image question > Flashcards
Image question Flashcards
(1 cards)
1
Q
What does this image show?
A
How well did you know this?
1
Not at all
2
3
4
5
Perfectly
Decks in class (108)
# Cards
-
Anterior versus posterior pituitary gland products1
-
Embryonic precursor of anterior pituitary1
-
Vibrio Cholera causes for diarrhea.3
-
Organs that carry out gluconeogenesis1
-
Cytokines that recruit different cell types1
-
Pro-inflammatory cytokines1
-
Cytokines that stimulate cachexia--weight loss, muscle atrophy, and fatigue during chronic disease (eg, cancer, AIDS, heart failure, COPD)1
-
Anti-inflammatory cytokines1
-
Common infectious causes of granulomas1
-
Common noninfectious causes of granulomas3
-
Major types of antigen-presenting cells1
-
Major dermatome landmarks1
-
Spinal nerve roots of genitofemoral, femoral, and sciatic nerves3
-
Common cause of painful bulging anal mass1
-
Th1 and Th2 cell function1
-
Cells and cytokines involved in granuloma formation1
-
Type 2 pneumocyte location1
-
Effect on ADH, Central blood volume, and ANP after 20 min cold water submersion1
-
Poison ivy rash (to urushiol) relation to HSR1
-
Male/female genital analogs1
-
Female paramesonephric/Mullerian duct derivatives1
-
Male mesonephric/Wolffian duct derivatives1
-
Major biochem deficiencies and symptoms1
-
Whipple disease and sx2
-
Tumor causing microbes1
-
MOA and toxicities of chemo and immunosuppressive agents13
-
MOA of most common immunosuppressants1
-
Common B-cell immune-deficiency syndromes1
-
Common T-cell immune-def. syndromes4
-
Common combined B-cell and T-cell disorders5
-
Most common phagocyte immunodeficiencies4
-
Pt’s without/with decreased B-cells and their infection risk1
-
Porphyrias2
-
Mechanisms and enzymes involved in Osteogenesis imperfecta1
-
Results of UMN lesions1
-
Types of hypercholesterolemia1
-
Fibrates1
-
Nicotinic acid=Niacin=B31
-
Ezetime1
-
Cholestyramine, cholestipol, and colesevlam1
-
Statins1
-
PCKS9 inhibitors1
-
Treatment for mild cholesterol gallstones1
-
Hypertriglyceridemia1
-
Heart chamber closest to esophagus1
-
Heart chamber closest to front of chest1
-
SA node1
-
Differences between types of Mycobacterium leprae1
-
Coagulation cascade1
-
Bleeding time1
-
Fibrinogen factor1
-
Disseminated intravascular coagulation (DIC)3
-
Congenital adrenal enzyme deficiencies2
-
The Brain1
-
Brain fill in the blank1
-
Corticospinal tract fiber origins1
-
Lobes and cortexes3
-
MLF lesion2
-
Differences between Contralatral hemiballismus versus Huntington’s disease2
-
Respiratory compensation1
-
Tricuspid valve murmur1
-
E.Coli virulence factors1
-
Superantigens2
-
Cerebral hematomas1
-
Type of hematoma1
-
Skeletal muscle activation MOA1
-
Hemochromatosis sx and lab sx1
-
Image question1
-
Bullous pemphigoid and pemphigus vulgaris1
-
Nitrosamines, aflatoxin, and glue inhalation toxicity1
-
Splenic infarct1
-
Hypocalcemia and hypercalcemia1
-
Hypokalemia and hyperkalemia1
-
Enzyme test for gram-positive bacteria1
-
Uteran and ovarian arteries1
-
Aledronate1
-
Heparin and warfarin1
-
Physiology of ejaculation1
-
Parasympathetic nerve supply to hindgut1
-
Cavernous sinus1
-
Skin cancer1
-
Skin cancer 21
-
Skin cancer 31
-
Skin cancer appearances1
-
Merkel cell carcinoma1
-
Skin condition1
-
Actinic keratosis1
-
Ankylosing spondylitis1
-
Image question 21
-
Tactile fremitus1
-
Most common paraneoplastic syndrome associated with small cell lung cancer1
-
Thyroid-binding globulin production1
-
Pulmonary capillary wedge pressure=pulmonary artery occlusion pressure1
-
Estrogen and liver failure1
-
Aortic stenosis and aortic regurgitation/insufficiency1
-
Crystals and polarized light1
-
Ichen sclerosis1
-
K+ sparing diuretics2
-
Loop diuretics2
-
Carbonic anhydrase inhibitors2
-
Polysaccharide antigen vaccine1
-
IV saline concentration1
-
hCG function in men1
-
Clinical trail stages1
-
Clinical trail question1
-
Upper motor neuron lesions and hyperreflexia/hyporeflexia1
-
Metastasizing of carcinomas and sarcomas2
-
Fungin antifungal mechanism1


